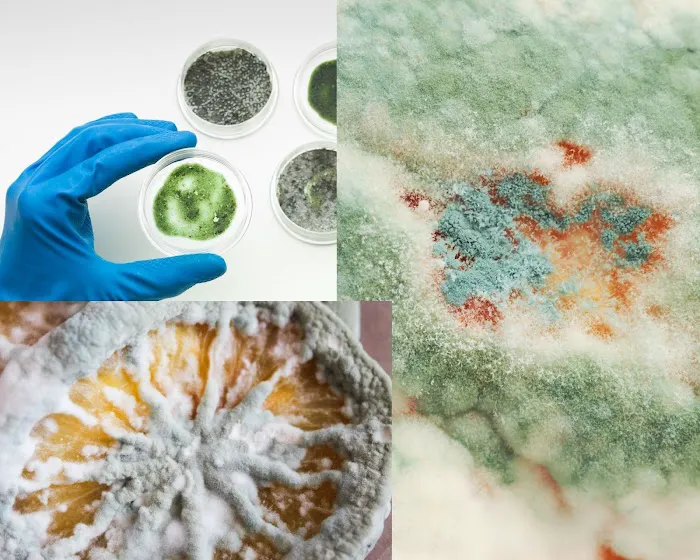
H2O Mold Restoration Gurus of Rancho Santa Margarita Picture 2

H2O Mold Restoration Gurus of Rancho Santa Margarita Photos

H2O Mold Restoration Gurus of Rancho Santa Margarita Introduce
For homeowners and property managers in the beautiful community of Rancho Santa Margarita, California, unexpected property damage from water can be a major source of stress and disruption. A burst pipe, an overflowing sink, or a hidden leak can quickly lead to extensive damage to floors, walls, and personal belongings. This is where H2O Mold Restoration Gurus of Rancho Santa Margarita stands out as a premier "point of interest" for anyone in the area seeking a swift and professional solution. While not a typical tourist destination, this business is a crucial resource for those in a moment of crisis, offering peace of mind and expert assistance. They are the go-to experts you turn to when your property needs to be meticulously restored and brought back to life after a water incident. H2O Mold Restoration Gurus has built a strong reputation for its exceptional professionalism, fast response times, and a genuine commitment to customer satisfaction. Their team of skilled professionals is not only knowledgeable and efficient but also deeply committed to providing compassionate and clear service from start to finish. They understand that a home is more than just a building; it's a personal sanctuary, and their mission is to restore that sense of safety and normalcy as quickly as possible. Their approach is both systematic and personal, ensuring that every project is handled with meticulous care and attention to detail. For anyone in California facing a property disaster, knowing that a trusted partner like H2O Mold Restoration Gurus is available provides immense peace of mind. They are a local company with strong roots in the community, and their understanding of the unique challenges and opportunities that come with properties in this region makes them an invaluable resource. They are more than just a service provider; they are a partner in helping you rebuild, restore, and improve your property. The peace of mind that comes from knowing your project is in capable hands is invaluable, and this is exactly what H2O Mold Restoration Gurus aims to provide to every single client. Their process is designed to be transparent and stress-free, ensuring you are informed and comfortable at every stage of the work. This dedication to a positive customer experience is a cornerstone of their business philosophy and a major reason why they have become a trusted name in the community. Their deep roots in the California region mean they are not just serving customers; they are serving neighbors and fellow community members, a distinction that is reflected in the quality of their work and their sincere commitment to getting every job done right.
H2O Mold Restoration Gurus of Rancho Santa Margarita is conveniently located at 38 Las Castanetas, Rancho Santa Margarita, CA 92688. This strategic location provides them with easy access to a wide service area, allowing them to respond quickly and efficiently to emergencies throughout Orange County. When a water leak or flood occurs, time is of the essence, and their central positioning ensures that their expert crews and specialized equipment can be deployed without delay. For residents in Rancho Santa Margarita, Mission Viejo, Ladera Ranch, and surrounding communities, this means they can count on a rapid response when they need it most. The accessibility of their office along Las Castanetas makes it simple for their team to navigate the local roads and major highways, ensuring a fast arrival at your property. This local presence is a significant advantage, as it means the team is not only geographically close but also deeply familiar with the specific building codes, environmental factors, and community needs of the region. They are not a faceless corporation; they are an integral part of the Rancho Santa Margarita community, with a deep understanding of the local landscape and its challenges. This familiarity allows them to provide a more tailored and effective service, addressing the unique issues that California properties often face. This community-centric approach is woven into the fabric of their operations and contributes to the high level of trust they have earned over the years. When you choose H2O Mold Restoration Gurus, you're not just hiring a contractor; you're supporting a local business that is invested in the well-being and prosperity of the area. Their proximity and familiarity with the area are invaluable assets that benefit every client they serve, ensuring a fast, efficient, and well-executed response to any water-related disaster.
H2O Mold Restoration Gurus of Rancho Santa Margarita offers a comprehensive suite of services focused on the professional restoration of properties affected by water and mold. Their expertise is centered on these specific areas, allowing them to provide a level of detail and knowledge that is crucial for effective and long-lasting results. Their services are designed to address all phases of a water damage project, from the initial emergency response to the final repairs, providing a seamless and stress-free experience for their clients. This all-in-one service model is a significant advantage, as it removes the burden of a homeowner having to find and coordinate with multiple different companies for various stages of the project. The team at H2O Mold Restoration Gurus is composed of highly trained and certified professionals who utilize state-of-the-art equipment and techniques to ensure the job is done right. They are committed to staying up-to-date on the latest industry standards and best practices, which allows them to deliver the highest quality service. Their services are crucial for protecting a property's structural integrity and for ensuring a healthy living environment. The presence of water and moisture can lead to serious secondary damage, such as mold growth, which requires a specific and professional approach to remediation. H2O Mold Restoration Gurus is well-equipped to handle these complexities, providing peace of mind to homeowners who might otherwise be overwhelmed. Their dedication to providing a full spectrum of specialized services makes them an invaluable resource for the local California community. They are ready to assist at a moment's notice, understanding that these situations are often urgent. The team's capability to handle a diverse range of water and mold-related issues makes them a true partner in property care and restoration, providing expert solutions that are both effective and reliable.
Water Damage Restoration: Quick and effective response to water leaks, flooding, and pipe bursts, including water extraction, drying, and dehumidification.
Mold Remediation: Professional and safe removal of mold from affected areas, including containment, air purification, and sanitization to ensure a healthy living environment.
Structural Drying: Advanced drying techniques for hidden moisture in walls, floors, and other building materials to prevent long-term damage and microbial growth.
Emergency Services: 24/7 availability for immediate response to water-related emergencies, minimizing damage and speeding up the recovery process.
Property Restoration: Comprehensive services to restore affected areas of a home or business, from floors to other appliances, back to their original condition.
The exceptional features of H2O Mold Restoration Gurus of Rancho Santa Margarita are best showcased through the positive experiences of their clients, which highlight their professionalism and commitment to quality. A review from a customer who experienced an overflowing kitchen sink praises the company for responding "so promptly" and doing the job "seamlessly and clean." The customer was particularly impressed with how the team restored their floors "like new." This attention to detail and ability to deliver a pristine final result is a powerful feature that resonates deeply with property owners. The review concludes with a strong endorsement, stating that the customer has "already referred them to several friends and neighbors." This word-of-mouth recommendation is the ultimate testament to the quality of their work and customer satisfaction. Another customer review further emphasizes the company's strengths, noting that they "preferred to use the service of this company, out of the water damage and restoration companies in our town." The review highlights the "very committed" dedication of their people to their work and describes them as "well experienced and highly trained." These firsthand accounts collectively demonstrate several key features: a professional and prompt response, a team of dedicated and highly experienced professionals, a meticulous approach to work, and the ability to restore properties to their pre-damage condition, or better. The company's focus on being the "best for me" among local competitors, as stated in one review, shows their commitment to providing a superior service. Their ability to take a chaotic and overwhelming situation and transform it into a structured, manageable process is a testament to their professionalism and expertise. They are not just restoring properties; they are restoring normalcy and peace of mind for their clients, and this is a truly invaluable service that provides a great sense of security. Their dedication to delivering on their promises and exceeding expectations is what makes them a trusted and recommended choice within the local community. This blend of technical skill, dedicated service, and local trust is what truly sets them apart as a leader in their field.
Prompt and Professional Response: Customers appreciate the quick action and professional conduct of the team, which is crucial for mitigating damage in water-related emergencies.
High-Quality Workmanship: Reviews highlight the team's ability to perform jobs "seamlessly and clean" and restore floors "like new," demonstrating their meticulous attention to detail.
Highly Trained and Experienced Staff: The company is praised for having dedicated, well-experienced, and highly trained professionals who are committed to their work.
Local Community Trust: The fact that customers recommend them to friends and neighbors shows the high level of trust they have earned within the Rancho Santa Margarita community.
Effective Problem Resolution: The team effectively addresses the core issue, from an overflowing sink to severe floor damage, providing a comprehensive solution.
For those in Rancho Santa Margarita and the surrounding areas who are in need of water damage or mold restoration services, H2O Mold Restoration Gurus is easy to contact. Their team is ready to answer your questions, provide expert advice, and schedule an on-site visit to assess your needs. Their main office is located at 38 Las Castanetas, Rancho Santa Margarita, CA 92688. To get in touch with their knowledgeable and responsive staff, you can call their main phone number at (949) 704-6595. They also provide a mobile phone number, +1 949-704-6595, which is particularly useful for direct and urgent communication. The team is dedicated to providing prompt and courteous service, and they understand that clear communication from the very first contact is essential. They are prepared to listen to your concerns, assess your situation, and provide a detailed and transparent plan of action. Their commitment to accessibility ensures that you can always get in touch with a professional who can help. Whether you are dealing with a sudden flood or a long-standing mold issue, reaching out to H2O Mold Restoration Gurus is the first and most crucial step toward a successful resolution. Their professionalism and readiness to assist make them a reliable pillar of support for anyone in the region facing property-related challenges, and they are always ready to help their community members in their time of need. Their responsiveness and availability are key components of their exceptional customer service, making them a reliable resource for any homeowner or business owner in the area.
In conclusion, for locals in the California region, especially in Orange County, H2O Mold Restoration Gurus of Rancho Santa Margarita is a vital resource for all water damage and mold restoration needs. While not a place you visit for leisure, it is a crucial destination for those seeking professional, reliable, and high-quality services in a time of need. Their strong local presence, combined with their extensive range of expert services and a proven track record of exceptional customer care, makes them an ideal partner for any property project. The glowing customer reviews highlighting their superb professionalism, rapid response, and compassionate guidance through stressful situations are a testament to their dedication. For Californians who take pride in their homes, H2O Mold Restoration Gurus offers a service that is both effective and empathetic, ensuring a swift and successful recovery. Choosing H2O Mold Restoration Gurus means choosing a company that is not just skilled but also genuinely cares about its clients and the community. Their ability to transform a traumatic event into a manageable and positive experience is what makes them so suitable for locals. They are more than a service provider; they are a trusted partner in protecting and restoring your most valuable asset. For any home or business owner in the area, H2O Mold Restoration Gurus is the name to remember for expert, compassionate, and efficient restoration services. They are a vital part of the community, helping to rebuild and restore with every project they undertake, providing peace of mind one home at a time.
H2O Mold Restoration Gurus of Rancho Santa Margarita Services
Water Damage Restoration Service
- Carpet cleaning
Carpet cleaning is an essential service to keep your home clean and comfortable. It is performed to remove stains, dirt, and allergens from carpets. Common methods include hot water extraction, dry-cleaning, and vacuuming.
- Fire damage cleanup & repair
- Flood cleanup
- Flood restoration
- Flooring
- Mold cleaning
- Mold damage restoration
- Mold inspection
- Mold remediation
- Plumbing
- Sewage cleanup
- Water damage-related cleanup & repair
- Water damage-related mold removal
- Water removal
- Air Conditioning System
- Air Ducts
- Air Filtration
- Air Scrubbers
- Black Mold
- Broken Pipe
- Burst Pipes
- Cleaning And Sanitizing
- Cleaning and Sanitizing
Cleaning and sanitizing a home or business after water damage is the process of removing contaminants that can cause health problems or lead to more extensive repair work down the line, as well as removing dirt and odors associated with mold growth.
- Cleanup And Restoration
- Commercial Property
- Complete Reconstruction
- Dehumidifier Systems
- Dehumidifying Cleaning
- Drying and Dehumidifying
Then comes drying and dehumidification. It is the third step in the water damage restoration process. This step is crucial to ensure that all materials are properly dried out and dehumidified to prevent further damage and growth of mold.
- Drywall Repair
- Electrical Wiring
- Fire Damage Cleanup
- Fire Damage Restoration Process
- Fire Damage Restoration Service
Fire damage restoration is the process of removing any fire and smoke damage to your home. It involves removing anything affected by the fire and smoke and repairing or cleaning what was left behind. Fire damage restoration is very important for both you and your family’s health and safety.
- Flooded Home
- Floor Coverings
- Free Estimate
- Hepa Filters
- Home Restoration
- Inspection And Assessment
- Inspection and Assessment
It is the first step in the water damage restoration process, saving time and money by doing it right the first time. This includes inspecting the home or building for water damage and assessing the degree of damage using specialized equipment such as hygrometers and moisture detectors.
- Insurance Claims
- Moisture Detectors
- Mold Damage Restoration
- Mold Detection
- Mold Growing
- Mold Remediation Service
Mold remediation is the process of cleaning up a house or building that has been exposed to mold. It is often necessary because of previous water damage or even a faulty air conditioning system.
- Mold Removal
Mold is also dangerous to your family’s pets and belongings because it can damage wood, fabric, carpeting, insulation, water-based paint and many more. You will need a thorough water extraction and mold removal service from the H2O Mold Restoration Gurus.
- Pressure Washers
- Professional Air Duct Cleaning Service
Air duct cleaning is an important activity that should be completed after fire damage restoration, mold remediation or water damage restoration. After a disaster, many individuals don’t bother paying attention to cleaning the air ducts.
- Residential And Commercial
- Restoration and Repair
The final phase of the water damage restoration process is Restoration and Repair. Restoration specialists return your home to its pre-damage state by repairing any damaged materials or replacing those that have been permanently removed.
- Sewage Backup
- Simple Repairs
- Smoke Damage Removal Service
- Soaked Carpeting
- Storm Damage
- Structural Damage
- Structural Drying And Dehumidification
- Water And Fire Restoration
- Water Damage From Firefighting
- Water Damage Inspection
- Water Detection
- Water Detectors
- Water Extraction
- Water Heaters
- Water Intrusion
- Water Leakage
- Water Leaks
- Water Mitigation
- Water Pipe
- Water Pipe Burst
- Water Purification
- Water Removal Cleaning
- Water Testing
- Windows And Doors
H2O Mold Restoration Gurus of Rancho Santa Margarita Details
Service options
- Onsite services
Accessibility
- Wheelchair accessible entrance
- Wheelchair accessible parking lot
H2O Mold Restoration Gurus of Rancho Santa Margarita Location
H2O Mold Restoration Gurus of Rancho Santa Margarita
38 Las Castanetas, Rancho Santa Margarita, CA 92688, USA
H2O Mold Restoration Gurus of Rancho Santa Margarita Reviews
company
★ 5★ 4★ 3★ 2★ 1Among most other water damage restoration companies here in Rancho Santa Margarita, H2O Mold Restoration Gurus of Rancho Santa Margarita was best for me. They responded to our call so promptly when I called them to deal with my overflowing kitchen sink which caused severe damage to the floors and other appliances. They did the job for us seamlessly and clean and restored the floors like new. I have already referred them to several friends and neighbors.
Feb 10, 2022 · Francisco ObrienWe preferred to use the service of this company, out of the water damage and restoration companies in our town. The dedication of their people to their work was very committed. They are also well experienced and highly trained people.
Feb 01, 2022 · Desiree Buchanan
More Water Damage Restoration Near Me
MasterTech Environmental Orange County5.0 (1 reviews)18 Saltillo, Rancho Santa Margarita, CA 92688, USA
Home Sweet Home Restoration5.0 (50 reviews)30162 Tomas, Rancho Santa Margarita, CA 92688, USA
Aussie Bay LLC5.0 (4 reviews)31912 Mill Stream Rd, Trabuco Canyon, CA 92679, USA
ServiceMaster Restoration by Emergency Management Team4.0 (2 reviews)19671 Descartes, Lake Forest, CA 92610, USA
Emergency Mold Restoration of Orange County0.0 (0 reviews)20331 Lake Forest Dr Suite C10, Lake Forest, CA 92630, USA
Rainbow Restoration of Orange County4.0 (87 reviews)26226 Enterprise Ct, Lake Forest, CA 92630, USA
Emergency Home & Water Damage of Orange County4.0 (84 reviews)20722 Linear Ln, Lake Forest, CA 92630, USA
Paul Davis Restoration of South Orange County5.0 (49 reviews)26233 Enterprise Ct, Lake Forest, CA 92630, USA
SERVPRO of Mission Viejo0.0 (0 reviews)23392 Madero, Mission Viejo, CA 92691, USA
ProCare Services, Inc.0.0 (0 reviews)23382 Madero Unit J, Mission Viejo, CA 92691, USA
SCL Restoration Services Inc.5.0 (1 reviews)23145 Los Alisos Blvd #298, Mission Viejo, CA 92691, USA
Tixan Construction5.0 (23 reviews)21502 Firwood, Lake Forest, CA 92630, USA
Categories
Top Visited Sites
First Response Restoration LLC4.0 (26 reviews)
DryStream Restoration5.0 (51 reviews)
Romexterra Construction Fire and Water Restoration Services of Chicago5.0 (225 reviews)
Property Craft of Loveland/Fort Collins, CO4.0 (20 reviews)
Southern Hue Services5.0 (88 reviews)
Servpro of Kansas City Midtown4.0 (195 reviews)Top Water Damage Restoration Searches
Trending Damage Repair Guides Posts
What to Do If Your Water Damage Is Caused by an Appliance: Step-by-Step Guide
Water Damage Repair for Subflooring Under Carpets
Effective Water Damage Repair for Garage Floors: Complete Guide
Water Damage Restoration for Apartments and Condos – Complete Guide
Top 5 Water Damage Restoration Myths Debunked
Water Damage Restoration for Hospitals and Healthcare Facilities: Essential Guide
